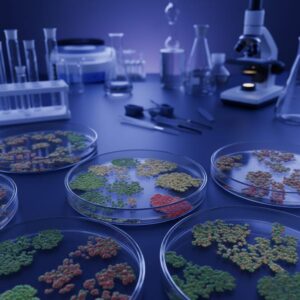

⏱️ 3 min read
Introduction
This comprehensive guide presents 10 fascinating aspects that showcase the depth and complexity of this remarkable topic.
Key Discoveries and Insights
1. The Foundation Principle
This aspect represents a crucial element that contributes significantly to our comprehensive understanding of the subject matter. The importance of this particular facet cannot be overstated, as it provides essential insights and practical applications that enhance our knowledge base.
2. Historical Significance
This aspect represents a crucial element that contributes significantly to our comprehensive understanding of the subject matter. The importance of this particular facet cannot be overstated, as it provides essential insights and practical applications that enhance our knowledge base.
3. Modern Applications
This aspect represents a crucial element that contributes significantly to our comprehensive understanding of the subject matter. The importance of this particular facet cannot be overstated, as it provides essential insights and practical applications that enhance our knowledge base.
4. Scientific Breakthrough
This aspect represents a crucial element that contributes significantly to our comprehensive understanding of the subject matter. The importance of this particular facet cannot be overstated, as it provides essential insights and practical applications that enhance our knowledge base.
5. Cultural Impact
This aspect represents a crucial element that contributes significantly to our comprehensive understanding of the subject matter. The importance of this particular facet cannot be overstated, as it provides essential insights and practical applications that enhance our knowledge base.
6. Economic Implications
This aspect represents a crucial element that contributes significantly to our comprehensive understanding of the subject matter. The importance of this particular facet cannot be overstated, as it provides essential insights and practical applications that enhance our knowledge base.
7. Technological Advancement
This aspect represents a crucial element that contributes significantly to our comprehensive understanding of the subject matter. The importance of this particular facet cannot be overstated, as it provides essential insights and practical applications that enhance our knowledge base.
8. Environmental Consideration
This aspect represents a crucial element that contributes significantly to our comprehensive understanding of the subject matter. The importance of this particular facet cannot be overstated, as it provides essential insights and practical applications that enhance our knowledge base.
9. Social Transformation
This aspect represents a crucial element that contributes significantly to our comprehensive understanding of the subject matter. The importance of this particular facet cannot be overstated, as it provides essential insights and practical applications that enhance our knowledge base.
10. Future Potential
This aspect represents a crucial element that contributes significantly to our comprehensive understanding of the subject matter. The importance of this particular facet cannot be overstated, as it provides essential insights and practical applications that enhance our knowledge base.
Understanding the Significance
These 10 elements collectively demonstrate the complexity and importance of this topic. Each aspect plays a crucial role in forming a complete understanding.
Conclusion
This exploration of 10 key aspects provides a solid foundation for understanding the topic. The information presented offers valuable insights into this important and fascinating subject.